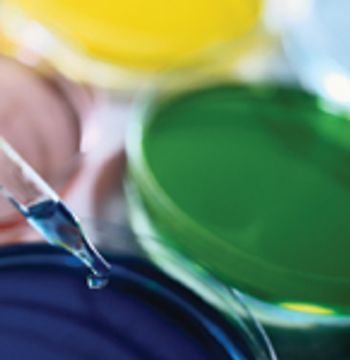
i1-316164-1408682402106.jpg

The biggest single recent trend in outsourcing solid-dosage processing has been the movement toward discovery and synthesis of more potent active pharmaceutical ingredients.

The biggest single recent trend in outsourcing solid-dosage processing has been the movement toward discovery and synthesis of more potent active pharmaceutical ingredients.

The construction of a new oral solid form (OSF) plant is an important decision and a real challenge. The team in charge of the basic conceptual design has to ensure that the new plant will be up-to-date and efficient not only at start-up, but for the next 15–20 years. This means that the project must be able to adjust to capacity changes, product changes and technology changes. It sometimes seems like an impossible challenge.

Bioequivalence with the reference product is the only reliable measure of demonstrating the therapeutic equivalence of a generic product to the innovator product. Systematic and comprehensive innovator product characterization can be used to make generic product development easier. This involves characterization of API and quantification of the critical excipients. The latter contributes towards performance of the final dosage form. This article describes the capsule formulation of a poorly water-soluble drug, celecoxib, which contains sodium lauryl sulphate as a critical excipient. The importance of a decoding process aimed at developing a generic product that matches the innovator formulation in a discriminating dissolution method is demonstrated.

On April 28, the US Food and Drug Administration's Center for Drug Evaluation and Research (Rockville, MD) issued a Warning Letter to Pliva Hrvatska d.o.o., a subsidiary of Pliva d.d. (Zagreb, Croatia).

Animal testing and accounting can both be hazardous.

Using Bezier curves, an experimental process controller has been developed for biosynthesis applications in which the inactivity of a pH-sensitive enzyme must be decreased. By taking into account various control scenarios of pH and growth rate, as well as the physical and chemical characteristics of the environment, a suitable human-machine interface can be developed.

Indian suppliers of active pharmaceutical ingredients and dosage formulations expand in India, the United States, and Europe.

Manufacturing and formulation innovation spurs drug develop-ment, but raises new safety and quality issues.

The author explores the importance of the proposals to revise Annex 1 of the EU GMPs in the context of the desire for science-based, internationally respected GMPs. Commentary also is provided about the relationship between this annex and CEN–ISO cleanroom standards.

This review article discusses orally disintegrating tablets and their manufacturing technologies, development issues, and future trends.

The common crystal form of ibuprofen was changed to optimize processing and manufacturing properties. Six modified crystal forms were prepared and assessed for dissolution, morphology, particle size, density, thermal characteristics, powder x-ray diffractometry, flow properties, and tabletability.

Being the first to gain the most is a fundamental principle in the generics business because several companies compete to create generics of successful products going off patent. For a generics company to maintain revenue growth in a market in which product prices continue to fall, it must secure a continuous flow of new products, with quality and speed to market being key drivers. Thus, generics companies must be highly skilled in product and process development (1), the generics business, and achieving bioequivalence-the most critical development area.

New biocatalytic and chemocatalytic routes to chiral intermediates and developments in simulated-moving-bed and supercritical-fluid chromatography for resolving racemic mixtures.

The need to curb drug counterfeiting is spurring development of track-and-trace and product authentication technologies.
Performing D-value and population verification is critical in the acceptance criteria for allowing a new lot of biological indicators into a facility before acceptance and use of the lot in validation work or routine monitoring of sterilization cycles.

Absorption promoters and enhancers and enzyme inhibitors, either alone or in combination, can play an important role in improving the bioavailability of oral insulin.

Could compounds in chocolate yield new pharmaceutical approaches to major disorders?

All sectors of manufacturing are under continual pressure to bring new products to market quicker, stealing a march on the competition and maintaining their revenue stream.

The discovery of suitable lead structures for new drugs from an inexhaustibly large reservoir of theoretically possible compounds is one of the biggest challenges for the pharmaceutical industry. In the last few years, combinatorial chemistry methods have been developed to synthesize a huge amount of diverse new chemical entities (NCEs), which may subsequently be tested for biological activity in vitro.

Pellets are a multiparticle, solid form of medication. The individual pellets are almost spherical with diameters usually between 100 and 2000 ?m.

New Biodegradable Polyketals Developed for Drug Delivery

Facing still-sluggish market conditions and a changing world order in fine chemicals, the large Western custom manufacturers are responding by building their toolboxes in specialized technologies in chiral chemistry, catalysis, and biosciences and by adjusting their manufacturing networks via streamlining or investment in Asia.

Adding a cleaning step to the field-testing protocol, and combining it with the data generated to register sanitizing and disinfectant agents under FIFRA and the CEN TC 216 work program, produces a sanitation-and-disinfection validation methodology that is cost-effective, simple, and time-saving.

Polymorph farming on a chip is a promising strategy for rapid polymorph discovery by transforming crystallization?crystal isolation?characterization into one time-efficient step.

A modified modular high-pressure system can form nanosuspensions of model compounds by individually controlling cavitation, impact, and shear forces.